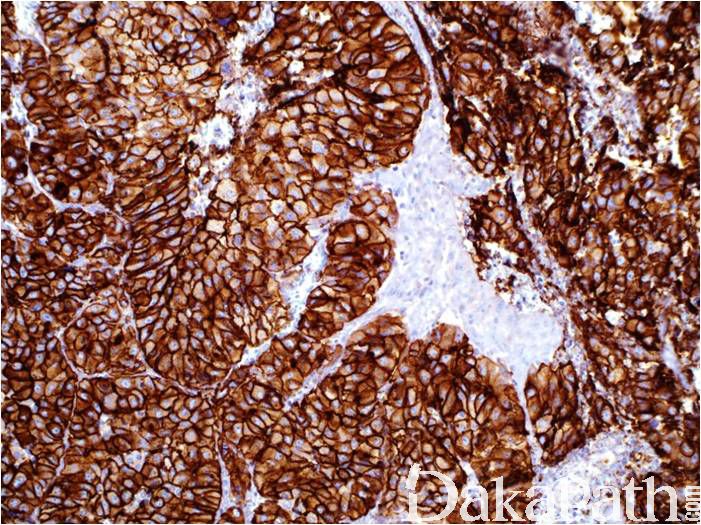

Glypican-3
概述:
肝细胞癌标记物,非癌阴性,分化越高表达越强。
信号定位: 胞浆、胞膜
在病理学中的应用:
肝细胞癌(+)与胆管细胞癌的鉴别诊断;
肝细胞癌(+)与肝细胞腺瘤(-)的鉴别诊断,分化越高,表达越强。
- Distinguish hepatocellular carcinoma (usually GPC3+) from non malignant liver (GPC3-) as part of a panel (Am J Clin Pathol 2008;130:219, Am J Surg Pathol 2008;32:433), but cirrhotic nodules may show focal strong staining (Mod Pathol 2008;21:1011)
- Distinguish hepatocellular carcinoma from other primary and metastatic hepatic lesions by FNA (Mod Pathol 2008;21:626)
- Distinguish ovarian yolk sac (GPC3+) from embryonal carcinoma (GCP3-) as part of a panel (Hum Pathol 2010;41:716)
商品化试剂(排名不分先后,本网站对抗体质量不负责!)
公司 | 克隆号 | 即用型(ml) | 原液(ml) | ||||
基因科技 | 1G12 | / | 2 | 4 | 7 | / | 0.2 |
赛诺特 | 1G12 | 1 | 3 | 6 | / | 0.1 | 0.2 |
安必平 | 1G12 | 1.5 | 3 | 6 | / | 0.1 | 0.2 |
← Galectin-3 Heparanase →